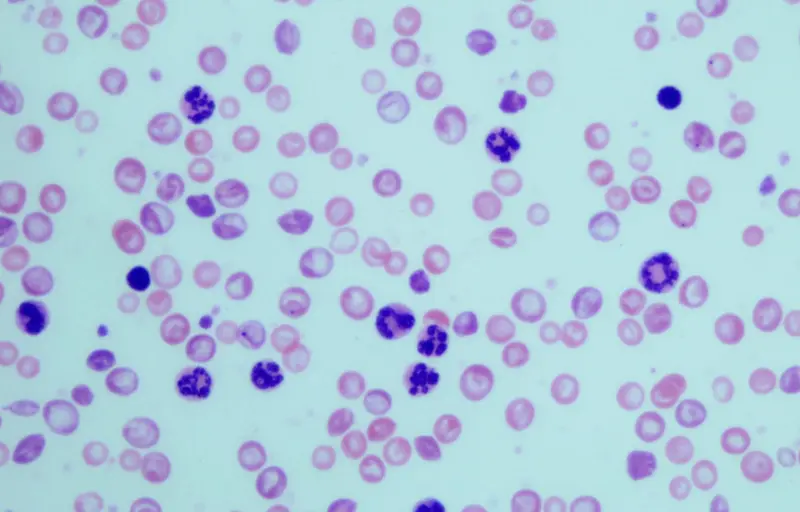
<p> Granulocitos en muestras sangu&iacute;neas de ratones con leucemia mielog&eacute;nica cr&oacute;nica. - CSIC </p>

El CSIC descubre el papel de una proteína clave en el desarrollo de la leucemia mielogénica crónica
Un equipo de investigadores liderado por el Consejo Superior de Investigaciones Científicas (CSIC) ha descubierto que la proteína SOS1 es necesaria para desarrollar leucemia mielogénica crónica, un tipo de cáncer en el que la médula ósea produce demasiados glóbulos blancos.
Este hallazgo, publicado en la revista 'Cancers', ofrece una vía novedosa en el diseño de nuevos fármacos que podrían ser útiles en los casos de resistencia a tratamientos crónicos como el Imatinib u otros inhibidores tirosina-quinasa.
Y es que, el 90 por ciento de las personas con leucemia mielogénica crónica tiene una mutación genética que se llama cromosoma Filadelfia. Una sección del cromosoma 9 (ABL) y una sección del cromosoma 22 (BCR) se rompen e intercambian lugares. El gen BCR-ABL se forma en el cromosoma 22, donde se une a la sección del cromosoma 9, y este cromosoma 22 alterado se denomina cromosoma Filadelfia.
Trabajos previos desarrollados in vitro e in vivo por el grupo de Eugenio Santos en el Centro de Investigación del Cáncer de Salamanca (CIC-CSIC-US), instituto mixto del CSIC y la Universidad de Salamanca, habían demostrado la relevancia de la familia de proteínas SOS en el desarrollo de cáncer de piel y otros estudios habían vinculado la proteína SOS1 con la leucemogénesis mediada por el gen BCR-ABL.
En esta nueva investigación se ha empleado un modelo murino en el que los animales son portadores de la oncoproteína p210BCR/ABL y deficientes para la expresión de las proteínas SOS. "Nuestros datos muestran que la ablación genética directa de SOS1 provoca la supresión significativa de todas las características patológicas típicas de la leucemia mielogénica crónica, como el recuento leucocitario en sangre periférica y la capacidad de formación de células madre hematopoyéticas de la médula ósea, lo que demuestra que la deficiencia de esta proteína protege contra el desarrollo de la enfermedad", han dicho los expertos.
El trabajo contribuye a la suma de evidencias que proponen la inhibición de SOS1 como un enfoque terapéutico novedoso para el tratamiento del cáncer, ya que los ensayos in vitro e in vivo, fases previas para desarrollar un ensayo clínico en personas, ayudan a comprender los factores implicados en el desarrollo y progresión de la enfermedad y permiten sentar las bases para su prevención y tratamiento.





